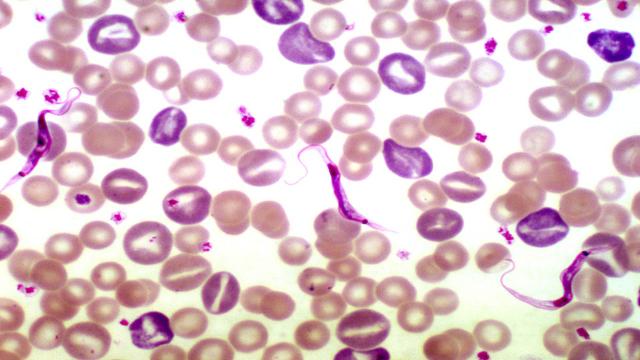
Herbs and spices for parasite removal and improved health

Parasites are organisms that live on or in a host organism and derive their nutrients at the expense of their hosts. These Parasites can be picked up through food, water, poor hygiene, poor sanitation or by living with animals, especially dogs. They affect the blood, eye, heart, intestine to mention a few and can cause various diseases. Though it is believed that these parasites rarely kill, the truth is that they actually do.
Fortunately, Mother Nature has provided us with natural and effective remedies to fight these parasites.Here are powerful herbs that target, suppress and kill parasites in human body
1. Fresh Garlic
This potent herb contains allicin and ajoene, two active components that can get rid of any unwanted organism in the body.
It kills parasites, detoxifies the body, stimulates toxin removal and protects the body against oxidation caused by parasite toxins. This common household herb is very Powerful and should never be underestimated
2. Cucumber seeds
Cucumber seeds have both curative and preventive properties. The powder of these seeds can be used to eliminate parasites, especially tapeworm from the digestive tract.
3. Papaya seeds
Although it is commonly advised that sugary tropical fruits should be avoided when dealing with intestinal parasites, papaya is an exception to that. The seeds of this fruit are very powerful in the elimination of intestinal parasites. According to a report from the University of Maryland, a mixture of honey and papaya seeds has been found effective in the total removal of parasites from the intestine.
4. Cloves
Cloves contain eugenol and caryophyllene, two powerful germicidal and antimicrobial agents which have been confirmed to be very effective in the killing of parasites, their larvae, and eggs.
5. Ginger
Ginger has anti-microbial and worm-expelling properties. It has both curative and preventive properties. Ginger improves stomach acid production which kills parasites and protects the host from getting infected again.
6. Green hulls of black walnut
The dried and ground green hulls of Black Walnut contain juglandin and an organic iodine known as tannin which is very effective in killing many varieties of parasites. Also, black walnut kills parasites and help in the removal of toxins from the body.
It is very important to know that parasite killing herbs kill and eliminates good bacteria as well. Therefore, it is advised to take probiotics, a substance which stimulates the growth of microorganisms with beneficial properties, at the end of the day during a parasite herbal therapy.
![How to kill parasites naturally. [Image via By Roland Yao Wa Kouassi, Scott William McGraw/Wikiemedia] How to kill parasites naturally. [Image via By Roland Yao Wa Kouassi, Scott William McGraw/Wikiemedia]](https://staticr1.blastingcdncf.com/media/photogallery/2018/1/27/660x290/b_502x220x82/how-to-kill-parasites-naturally-image-via-by-roland-yao-wa-kouassi-scott-william-mcgrawwikiemedia_1799553.jpg)